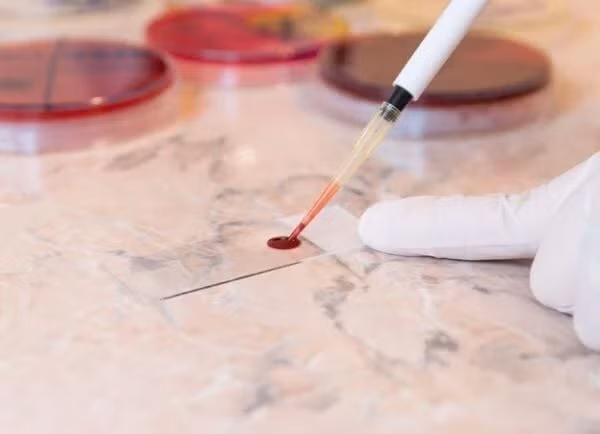
Trien vong ve phuong phap chua tri benh ung thu mau ac tinh-Hinh-5

Những bệnh nhân mắc đa u tủy kháng trị giờ đây đã có hy vọng sống sót. Các nhà nghiên cứu đang thử nghiệm loại thuốc mới và nhận được nhiều kết quả khả quan. Ảnh: Cancerhealth.
Đa u tủy là căn bệnh ung thư tế bào plasma. Những tế bào này có nguồn gốc từ tủy xương và là một phần quan trọng của hệ thống miễn dịch. Theo Hiệp hội Ung thư Mỹ, tỷ lệ mắc đau tủy là khoảng 1/132. Căn bệnh này hiếm khi được chẩn đoán ở những người dưới 65 tuổi.
Các tế bào plasma khỏe mạnh tạo ra kháng thể để chống lại bệnh tật. Còn các tế bào plasma ung thư tạo ra M-protein. Đây là các kháng thể bất thường và không có chức năng bảo vệ cơ thể khỏi nhiễm trùng. Các tế bào ung thư u tủy cũng tích tụ trong tủy xương và hình thành khối u.
Các tế bào plasma bất thường được hình thành từ các tế bào gốc trong tủy xương. Khi số lượng của chúng tăng lên, số lượng tế bào hồng cầu, tế bào bạch cầu và tiểu cầu sẽ giảm vì tế bào plasma và những tế bào trên đều được tạo nên từ cùng loại tế bào gốc.

Các tế bào plasma bất thường sinh sôi rất nhanh. Chúng tạo ra loại kháng thể không chống lại nhiễm trùng. Ảnh: Dxline.info.
Trong giai đoạn điều trị đầu tiên, các bác sĩ sẽ sử dụng hóa trị, liệu pháp miễn dịch và điều trị bằng corticosteroid. Một số người sau đó có thể sẽ được cấy ghép tế bào gốc của chính họ hoặc tế bào gốc được hiến tặng để giúp cơ thể sản xuất các tế bào máu khỏe mạnh.
Các phương pháp điều trị khác tập trung vào việc giảm triệu chứng bệnh để cải thiện chất lượng cuộc sống của bệnh nhân. Mặc dù các bác sĩ có thể điều trị và kiểm soát bệnh, họ vẫn chưa tìm ra cách trị dứt điểm bệnh đa u tủy. Bệnh đa u tủy được gọi là u tủy kháng trị nếu các tế bào ngừng phản ứng với việc điều trị.
Tiến sĩ Marianne Baker, quản lý thông tin nghiên cứu tại tổ chức Ung thư Nghiên cứu Anh nói: "Đa u tủy ảnh hưởng đến khoảng 6.000 người ở Vương quốc Anh mỗi năm, gây ra hơn 8 ca tử vong mỗi ngày. Các chuyên gia rất cần những liệu pháp mới để giúp những người mắc u tủy kháng trị".
Giờ đây, các thử nghiệm với kháng thể Talquetamab ở những người mắc u tủy kháng trị cho thấy kết quả đầy hứa hẹn. Sau khi được điều trị bằng thuốc miễn dịch trong thử nghiệm của hệ thống y tế Mount Sinai, gần 3/4 số người tham gia thấy bệnh tình cải thiện. 30% bệnh nhân có phản ứng tuyệt đối với thuốc.

Từ trước đến nay, đa u tủy là căn bệnh chưa có phương pháp chữa trị dứt điểm. Tuy nhiên, các nhà nghiên cứu đang thử nghiệm một loại thuốc đầy hứa hẹn, có thể cải thiện đáng kể căn bệnh ung thư máu này. Ảnh: Luis Velasco/Stocksy.
Kết quả của thử nghiệm giai đoạn 1 đăng tải trên chuyên san New England Journal of Medicine và kết quả thử nghiệm giai đoạn 2 được trình bày tại cuộc họp thường niên của Hiệp hội Huyết học Mỹ.
Talquetamab là kháng thể đặc hiệu kép, một loại kháng thể đơn dòng phụ trách chuyển hướng các tế bào T chống lại tế bào u nguyên bào.
Tiến sĩ Ajai Chari, Giám đốc nghiên cứu lâm sàng trong Chương trình Đa u tủy tại Viện Ung thư Tisch, tác giả chính của cả 2 nghiên cứu, giải thích với Medical News Today (MNT): “Về cơ bản, một bên của Talquetamab liên kết với các tế bào miễn dịch được gọi là tế bào T, và bên còn lại liên kết với tế bào ung thư u tủy. Khi Talquetamab đưa các tế bào T và khối ung thư tới gần nhau, tế bào T sẽ giải phóng các hóa chất chọc thủng màng tế bào ung thư giết chết tế bào ung thư”.
Tiến sĩ Baker tỏ ra lạc quan nhưng vẫn giữ thái độ thận trọng trước liệu pháp này: “Talquetamab dính vào cả tế bào miễn dịch tiêu diệt ung thư và tế bào u tủy, giúp hệ thống miễn dịch nhận biết và tiêu diệt ung thư. Phát hiện này quả là đáng khích lệ. Tuy nhiên, chúng ta cần thêm các nghiên cứu trước khi có thể sử dụng Talquetamab trong điều trị chính thức”.
Trong thử nghiệm giai đoạn 1, 232 bệnh nhân bị u tủy tái phát hoặc u tủy kháng trị được dùng Talquetamab. Các chuyên gia chia họ thành 2 nhóm: Một nhóm nhận thuốc qua đường tĩnh mạch và nhóm còn lại được tiêm qua da.
Kết quả thử nghiệm có tới 70% bệnh nhân phản ứng với thuốc. Thuốc cũng chỉ gây ra các tác dụng phụ nhẹ.

Tiến sĩ Ajai Chari, nhà nghiên cứu chính trong cả 2 giai đoạn thử nghiệm, cho biết phương pháp điều trị mới có rất ít tác dụng phụ và có kết quả tích cực với các bệnh nhân. Ảnh: Curetoday.
Tiến sĩ Chari giải thích: “Bệnh nhân u tủy kháng trị được coi là có phản ứng với phương pháp điều trị khi chỉ số phản ứng từ 50% trở lên. Sau khi nộp kết quả lên Cục Quản lý Thực phẩm và Dược phẩm, họ sẽ chỉ chấp thuận kết quả từ 50% cao lên, mọi chỉ số dưới 50% đều được coi là vô giá trị".
Ông nói thêm những bệnh nhân trong thử nghiệm thường đã trải qua tận 5 đợt trị liệu trong vài năm. Họ đã thử rất nhiều phương pháp nhưng đều không có kết quả khả quan. Vì vậy, trong hoàn cảnh đó, bệnh tình cải thiện 50% là điều thực sự tuyệt vời”.
Trong thử nghiệm giai đoạn 2, các bác sĩ thực hiện tất cả phương pháp điều trị dưới da với liều lượng thuốc an toàn và thành công trong thử nghiệm giai đoạn 1.
Thử nghiệm có sự tham gia của 288 bệnh nhân. 143 người trong số đó được nhận một liều thuốc duy nhất hàng tuần và 145 người còn lại nhận được liều thuốc gấp đôi sau mỗi 2 tuần.
Trong quá trình thử nghiệm, 73% bệnh nhân phản hồi tích cực với thuốc. Trong số đó, hơn 30% có phản ứng hoàn toàn, nghĩa là sau khi điều trị, các nhà nghiên cứu không thể phát hiện ra dấu hiệu cụ thể nào của u tủy. Gần 60% có “phản ứng tốt một phần”, nghĩa là bệnh ung thư của họ đã giảm đáng kể.
73% số bệnh nhân tham gia thử nghiệm có phản ứng tích cực với thuốc. Tình trạng ung thư của họ giảm đi đáng kể sau khi dùng thuốc. Ảnh: Yaktrinews.
Tiến sĩ Chari giải thích: “Phản hồi hoàn toàn không có nghĩa là bệnh nhân thực sự khỏi bệnh nhưng về cơ bản, liệu pháp làm giảm bệnh trạng xuống mức độ thấp tới nỗi không thể phát hiện được. Trong số những bệnh nhân có phản hồi tốt một phần, nhiều người đã cải thiện tới 90%".
Ông nói với MNT rằng các thử nghiệm giai đoạn 3 đang được tiến hành bằng cách sử dụng mô hình dùng thuốc 2 tuần một lần vì điều này thuận tiện hơn cho bệnh nhân. Hơn nữa, trong thử nghiệm giai đoạn 2, họ phát hiện việc sử dụng thuốc 2 tuần một lần giúp tác dụng của thuốc kéo dài lâu hơn việc dùng thuốc mỗi tuần.
Tiến sĩ Marianne Baker cho biết các thử nghiệm tương lai sẽ xem xét liệu phương pháp chữa u tủy bằng Talquetamab có thể áp dụng với nhiều bệnh nhân hơn không, đặc biệt là khi bệnh nhân cần kết hợp Talquetamab với các loại thuốc khác. Những thử nghiệm này có thể mang lại cơ hội sống lâu hơn cho những người mắc u tủy bằng cách ngăn chặn ung thư của họ trở nên trầm trọng hơn.
Tiến sĩ Chari nói: “Điều thú vị là những bệnh nhân ở độ tuổi cuối 60 đã được điều trị bằng rất nhiều liệu pháp trước đó. Chúng tôi thậm chí không nghĩ rằng các tế bào miễn dịch của họ sẽ hoạt động tốt như vậy vì họ đã phải trải qua quá nhiều lần điều trị. Nhưng giờ đây, chúng tôi đang thấy bệnh nhân phản ứng rất tốt, với chỉ số phản ứng 70-100%. Đây thực sự là một bước ngoặt".

Kết quả đầy hứa hẹn của thử nghiệm thắp lên tia hy vọng mới cho những người mắc đa u tủy. Ảnh: Cancertherapyadvisor.
Tỷ lệ phản ứng ở mức 73% cao hơn hầu hết kết quả của các liệu pháp hiện có. Vì vậy, các nhà nghiên cứu tin rằng Talquetamab có thể là lựa chọn khả thi cho những bệnh nhân u tủy kháng trị.
Tiến sĩ Chari nói ông và đồng nghiệp rất cần những liệu pháp như vậy. Phát hiện này sẽ mở ra một kỷ nguyên hoàn toàn mới cho việc điều trị ung thư.
Cuốn sách bên bờ sự sống
Ngành y là ngành luôn chứng kiến ranh giới sự sống - cái chết của người khác, nhưng Khi hơi thở hóa thinh không lại là một cuốn sách đặc biệt khi nó là khoảnh khắc đối diện cái chết của người viết trong cả vai trò bác sĩ lẫn bệnh nhân. Cuốn hồi ký được bác sĩ thần kinh Paul Kalanithi viết khi căn bệnh ung thư trở nặng, anh ngồi trên xe lăn và nhớ về những tháng ngày cống hiến cho ngành y.













![[INFOGRAPHIC] Bật mí thú vị về đồng hồ hạt nhân đầu tiên trên thế giới](https://cdn.kienthuc.net.vn/images/d7515ecfb15055b8d07daaaf3841815d4205c0debeb4efcf477768359328394daa349c57aad4218ca17950218c90bf106bce2d64a05d362503cb8e31529b3cc7/info-donghohatnhan-a-thumb.jpg.avif)


















